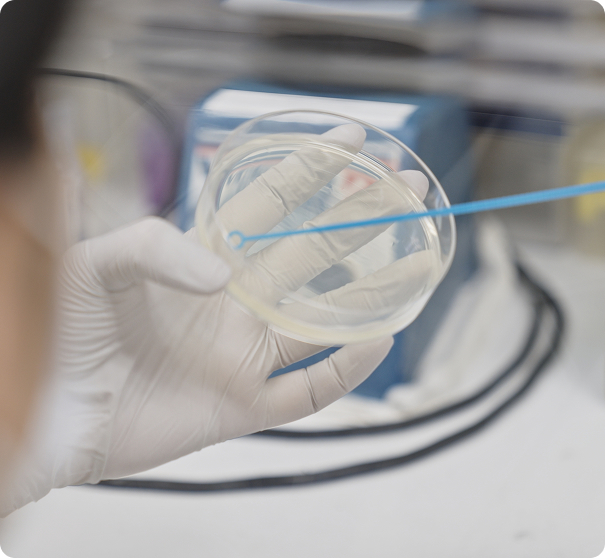
Our Current Challenge: Next-generation Product Development

Medical Foods Development

Working toward a society where everyone can pursue health without nutritional barriers.
Ippei Yamaoka
Director, Medical Foods Research Institute
The Role the Medical Foods Research Institute Should Fulfill in Today's Society

We aim to help build a society where no one who seeks better health is held back by disadvantages in their nutritional intake.
Despite significant advances in modern medicine, nutrition—though widely recognized as essential—still remains underutilized in clinical practice due to gaps in evidence-based application. At the same time, aging and illness can make appropriate nutritional choices increasingly difficult, leading to disparities in nutritional opportunities.
In this environment, our role is to deliver trusted, evidence-based options for nutritional intake that can be used with confidence across medical, caregiving, and everyday settings. We believe that returning the expertise and trust we have cultivated to society is the best way to enhance the value of our existing businesses, while expanding our activities into new medical and healthcare domains.
From the earliest stages of research, we prioritize designing products that can be used intuitively—whether by healthcare professionals, older adults, or family members.
In oral rehydration therapy, for example, our focus is not simply on “whether the patient can drink,” but on “whether we can help save the patient,” working to eliminate harm caused by incorrect choices.
In tube feeding, even seemingly small issues, such as diarrhea or aspiration, can undermine a patient’s will to live. Our mission is to enable nutrition management that minimizes the burden on patients, families, and healthcare professionals—and that can be continued safely and sustainably without unnecessary strain.
Looking ahead, through the research and development of foods grounded in medical and nutritional science, we will continue working to create an environment where everyone can approach both treatment and daily life with greater confidence. By providing trusted, reliable opportunities and options for nutritional intake across medical, caregiving, and everyday settings, we strive to support a society where nutrition empowers people rather than limits them.
What Sets a Pharmaceutical Research Institute Apart
The functions of our institute can be broadly categorized into three areas: research, product development, and social implementation. Research in medical foods involves evaluating and defining—based on medical knowledge and scientific evidence—what it truly means for a patient to consume a specific food. Our ultimate responsibility is to develop products that deliver consistent value regardless of who uses them or where they are used—whether in medical, caregiving, or everyday settings—and to establish systems that allow these products to be naturally and sustainably adopted by society.
We believe that advancing three elements as an integrated whole—research that seeks scientific truth, products that address real-world clinical needs, and social implementation that ensures these solutions reach people—is a distinctive approach that sets us apart from both food companies and academic institutions.
Our greatest strength lies in our ability to design foods and provide information grounded in a deep understanding of the decision-making criteria and real-world conditions faced by healthcare professionals, including physicians, nurses, pharmacists, and registered dietitians. Pharmaceutical research requires a rigorous ethical standard: results must not be overstated, inconvenient data must not be disregarded, and the limits of efficacy must be clearly communicated. Developing foods based on this ethical foundation has significant social value. It prevents the creation of unrealistic expectations among those seeking better health, enables healthcare professionals to recommend products with confidence, and helps sustain long-term trust in society.

Supporting Patients and Their Families in Sustaining Their “Strength to Live” and Their “Happiness”

What we mean by sustaining a person’s “strength to live” is not simply keeping someone alive. When aging or illness makes eating difficult—or turns meals into an ordeal—it can strip patients of their dignity and confidence. That is why we strive to make nutrition an “ally” rather than a “burden,” offering support tailored to each individual’s condition and delivered in a way that allows them to feel, without strain, “I can do this.”
Families who care for patients often carry their own anxiety and fear about whether they are making the right choices. By providing foods backed by clear medical and nutritional evidence—products that healthcare professionals can explain with confidence—we aim to ease that burden. We want families to feel reassured, empowered, and confident that their actions are genuinely helping.
The “joy” we seek to support is not limited to dramatic recoveries or better numbers on a chart. It includes the small sense of accomplishment that comes from being able to eat, and the comfort of being able to share everyday moments with family. Medical foods may not be the mainstay of treatment, but we believe they can serve as a catalyst for regaining daily life and as a bridge that connects people.
Through food, we remain committed to supporting quality of life (QOL) and helping create environments where patients and families can live with hope and a positive outlook.
The Culture We Value in Creating New Value
What matters most in research is not creating something on the assumption that it will probably help someone, but clearly defining whose challenges you are addressing and what kind of new future you intend to create. Without genuine needs in the field, the work cannot stand as a viable business. That is why we place great importance on identifying issues that are subtle and easily overlooked, or so large that people have already given up on them—and only then beginning research once we have fully made those challenges our own.
The true appeal of research lies in delivering outcomes that have no precedent. To achieve this, we encourage our members not to be constrained by past successes. Take initiative and act. Learn from failure when necessary. And maintain a mindset that goes beyond conventional wisdom.
The approach we take must also change depending on the nature of the business. In existing businesses that extend from past efforts, what is required is the ability to analyze history, forecast the future, and persistently pursue the goals ahead. In contrast, in new and uncharted areas where the right answer is unknown, it is essential to experiment first and pivot flexibly based on customer response.
People who are committed to achieving goals; people who create the future through their own initiative; and the colleagues who support them—together, we believe these individuals form the ideal foundation of a research institute.

Our Current Challenge: Next-generation Product Development
In a rapidly advancing super aged society, we aim to create a world where even those whose ability to eat has declined due to aging or medical treatment can continue to enjoy their daily meals. To achieve this, we are committed to developing products that not only meet nutritional requirements but also restore the “joy of eating”—the taste, aroma, and texture that make food meaningful.
While ensuring safety appropriate to each person’s swallowing function and chewing ability, we strive to recreate the flavors and aromas they naturally prefer and adjust texture to accommodate changes in eating pace and sensation. Our goal is to offer foods that people not only can eat, but genuinely want to eat. A decline in eating ability can happen to anyone, yet foods tailored to individual conditions and preferences remain limited. Guided by medical and nutritional evidence, we continue to pursue “deliciousness suited to eating ability.”
From a global perspective, nutritional needs differ widely by country and region. Asia faces challenges such as chewing and swallowing disorders and undernutrition among older adults; the United States is confronted by worsening obesity; Europe struggles with undernutrition linked to cancer and chronic diseases; and Africa and South Asia continue to face severe malnutrition and acute dehydration. In response, we conduct research and development tailored to regional characteristics and deliver products—including liquid diets and oral rehydration solutions—supported by the high quality, safety, and scientific evidence cultivated in Japan. Through this approach, we strive to meet nutrition related needs around the world.
Research and product development of medical foods
Drawing on our expertise in both medical care and nutrition—and grounded in the real challenges faced by patients and the realities of clinical practice—we are advancing the research, development, and social implementation of medical foods across a wide range of areas. The following sections introduce several of these initiatives.



